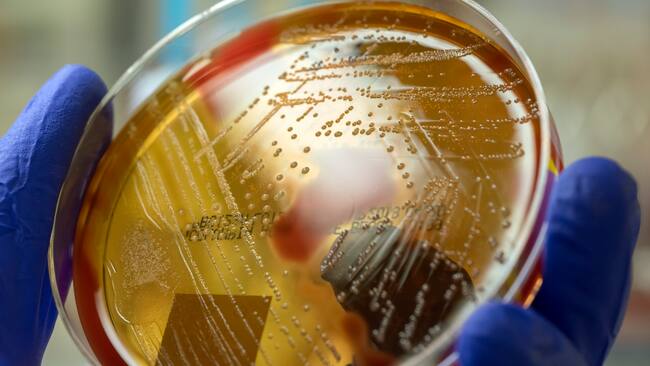
ADN

“Su frecuencia ha aumentado tras la pandemia”: subsecretaria de salud pública advierte sobre alza en casos de “bacteria asesina”
Sin embargo, afirmó que cuentan con un sistema de vigilancia y tratamiento establecido desde hace años. “Emitimos una alerta epidemiológica a finales de mayo para facilitar la detección precoz y el tratamiento oportuno”, dijo.

La subsecretaria de Salud Pública, Andrea Albagli, brindó importantes actualizaciones en materia de enfermedades respiratorias durante su visita al centro diurno del adulto mayor de San Joaquín. Todo esto, ante la solicitud de ampliación de grupos de vacunación.
Revisa también:
En ese contexto, la autoridad sanitaria destacó la respuesta previa del Ministerio de Salud, señalando que la ampliación ya se había realizado a comienzos y durante el verano, anticipándose a un invierno desafiante “modificando la edad mínima a 60 años, una medida que se respalda en nuestros datos de vigilancia. Al observar los sistemas de vigilancia de infecciones respiratorias agudas graves y el número de fallecidos por influenza este año, vemos que las personas mayores de 60 años son las más afectadas”.
Por otro lado, Albagli reafirmó la disposición del Ministerio a someterse a auditorías para revisar su trabajo: “Estamos completamente a favor. Valoramos cualquier proceso que revise nuestro trabajo en el Ministerio de Salud. Ya tenemos procesos de auditoría en curso, tanto en el Programa Nacional de Inmunizaciones como en otras áreas de nuestra labor habitual. Estamos dispuestos a colaborar plenamente con este proceso”.
En cuanto a la situación de camas críticas, la autoridad informó que la ocupación en el sector público para pediatría es del 70%, mientras que en el privado es del 73%, sumando un 70% en el sistema integrado. Para adultos, la ocupación es del 92% en el sector público y del 90% en el privado, alcanzando un total del 92% en el sistema integrado. La Subsecretaria recordó la alerta sanitaria emitida desde marzo, que facilita la gestión integrada de camas y permite traslados según la demanda y disponibilidad en distintas regiones.
Por otra parte, en relación con las hospitalizaciones por virus respiratorios, la profesional indicó que “aproximadamente, el 30% de las camas críticas para adultos se ocupan por estos casos, aunque esta cifra puede variar”.
“Respecto a la bacteria Streptococcus pyogenes, su frecuencia ha aumentado tras la pandemia. Sin embargo, contamos con un sistema de vigilancia y tratamiento establecido desde hace años. Emitimos una alerta epidemiológica a finales de mayo para facilitar la detección precoz y el tratamiento oportuno”, concluyó.
Sigue a ADN.cl en Google Discover
Recibe nuestros contenidos directamente en tu feed.























